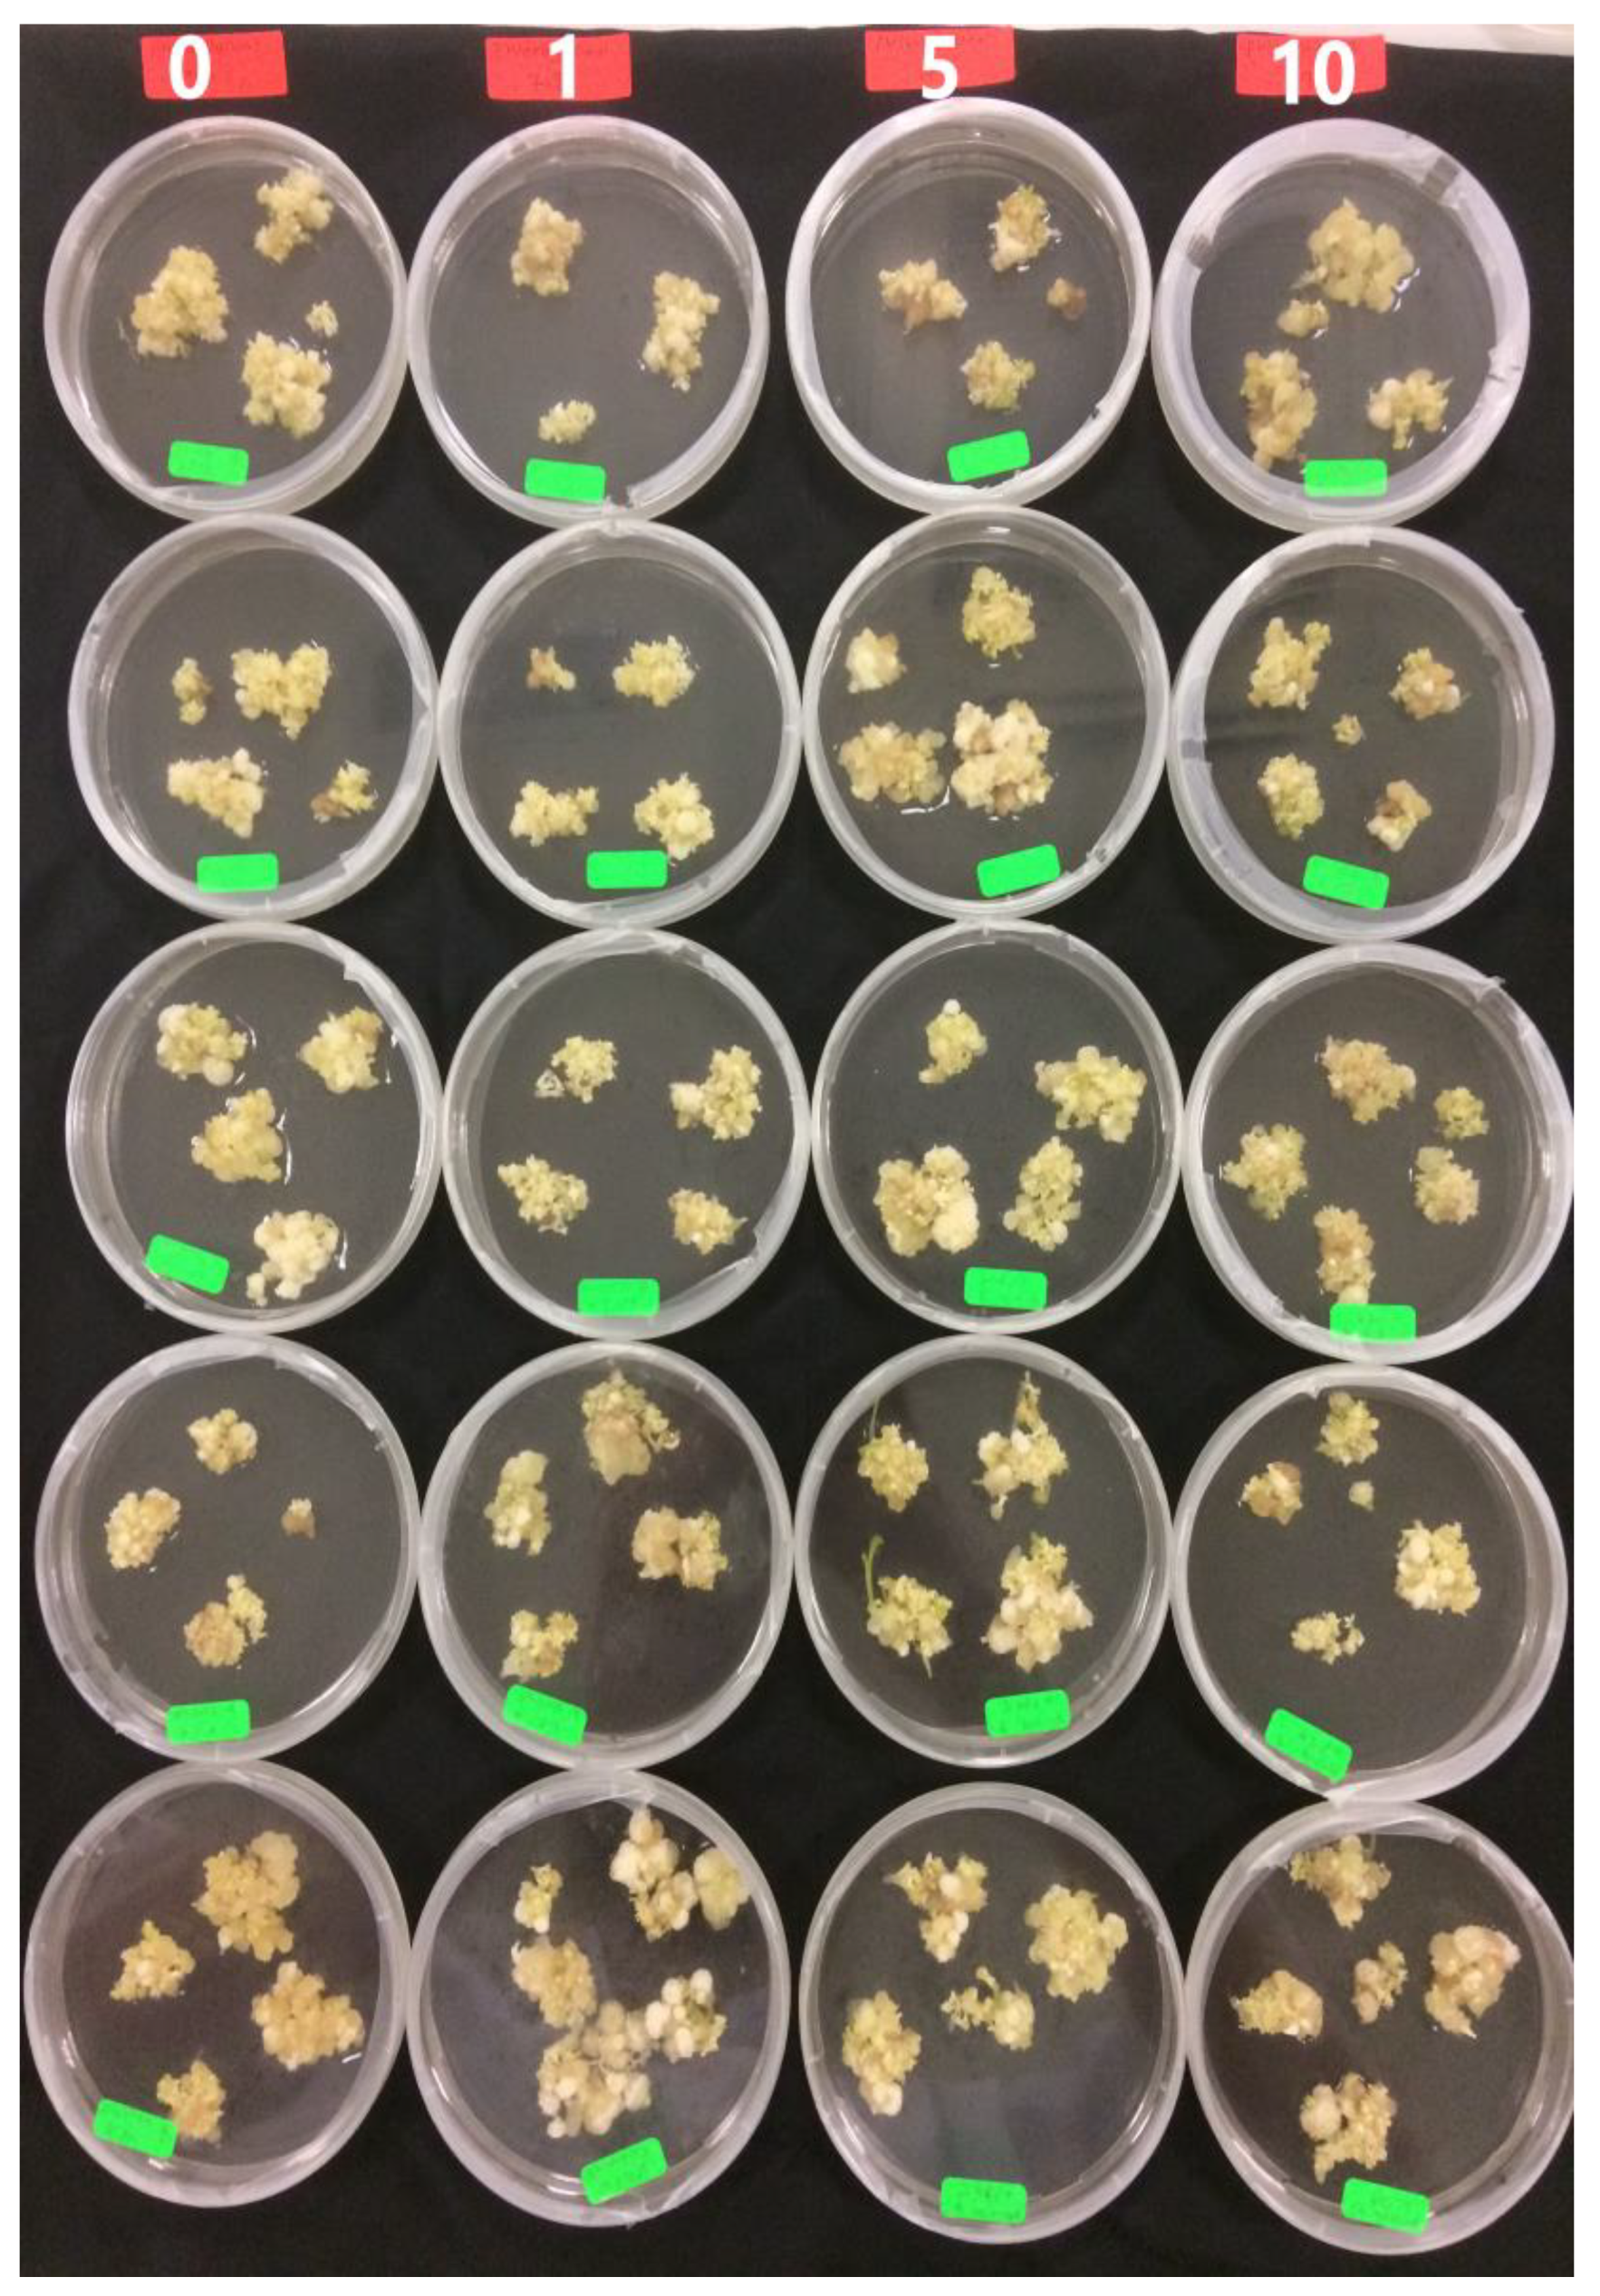
Plants 09 00360 g006

Figure 1.
General phases in somatic embryogenesis process.
Figure 1.
General phases in somatic embryogenesis process.
Figure 2.
The means of average callus weight (g) on different media supplemented with different 2,4-D concentrations after 6 weeks of culture. MS: Murashige and Skoog; WPM: McCown Woody Plant.
Figure 2.
The means of average callus weight (g) on different media supplemented with different 2,4-D concentrations after 6 weeks of culture. MS: Murashige and Skoog; WPM: McCown Woody Plant.
Figure 3.
The means of the somatic embryogenesis percentage on different media supplemented with different 2,4-D concentrations after 6 weeks of subculture.
Figure 3.
The means of the somatic embryogenesis percentage on different media supplemented with different 2,4-D concentrations after 6 weeks of subculture.
Figure 4.
Different developmental stages of somatic embryos during maturation phase: (A) globular shape (G) of somatic embryo, (B) heart shape (H) and mature cotyledon stage (MCo) of somatic embryo, (C) torpedo stage (T), late torpedo stage (LT) and mature cotyledon stage (MCo) of somatic embryos, (D) cotyledon stage (Co) and mature cotyledon stage (MCo) of somatic embryos, (E) somatic embryos with root (R), (F) somatic embryos with callus (Ca) at the base end.
Figure 4.
Different developmental stages of somatic embryos during maturation phase: (A) globular shape (G) of somatic embryo, (B) heart shape (H) and mature cotyledon stage (MCo) of somatic embryo, (C) torpedo stage (T), late torpedo stage (LT) and mature cotyledon stage (MCo) of somatic embryos, (D) cotyledon stage (Co) and mature cotyledon stage (MCo) of somatic embryos, (E) somatic embryos with root (R), (F) somatic embryos with callus (Ca) at the base end.
Figure 5.
Embryogenic callus after 6 weeks on maturation media supplemented with different concentrations of polyethylene glycol 8000 (PEG) (0, 2, 4, 8, 12%) (M1–M5).
Figure 5.
Embryogenic callus after 6 weeks on maturation media supplemented with different concentrations of polyethylene glycol 8000 (PEG) (0, 2, 4, 8, 12%) (M1–M5).
Figure 6.
Embryogenic callus after 6 weeks on maturation media supplemented with different concentrations of phloroglucinol (PG) (0, 1, 5, 10 mg L−1) (M6–M9).
Figure 6.
Embryogenic callus after 6 weeks on maturation media supplemented with different concentrations of phloroglucinol (PG) (0, 1, 5, 10 mg L−1) (M6–M9).
Figure 7.
C. papaya “Eksotika” in germination media A1, explant germinated in G1 media. A2, explant germinated in G2 media. B1, explant germinated in G3 media. B2, explant germinated in G4 media.
Figure 7.
C. papaya “Eksotika” in germination media A1, explant germinated in G1 media. A2, explant germinated in G2 media. B1, explant germinated in G3 media. B2, explant germinated in G4 media.
Figure 8.
C. papaya “Eksotika” in elongation media A1 and A2, explant germinated in EL1 media. B1 and B2, explant germinated in EL2 media.
Figure 8.
C. papaya “Eksotika” in elongation media A1 and A2, explant germinated in EL1 media. B1 and B2, explant germinated in EL2 media.
Figure 9.
C. papaya “Eksotika” in elongation media A1 and A2, explant germinated in EL3 media. B1 and B2, explant germinated in EL4 media.
Figure 9.
C. papaya “Eksotika” in elongation media A1 and A2, explant germinated in EL3 media. B1 and B2, explant germinated in EL4 media.
Figure 10.
C. papaya “Eksotika” (A) explants rooted in R1 medium, (B) explants rooted in R2 medium, (C) explants rooted in R3 medium, (D) explants rooted in R4 medium.
Figure 10.
C. papaya “Eksotika” (A) explants rooted in R1 medium, (B) explants rooted in R2 medium, (C) explants rooted in R3 medium, (D) explants rooted in R4 medium.
Figure 11.
C. papaya “Eksotika” after one month: (A) explants regenerated from R1 medium, (B) explants regenerated from R2 medium, (C) explants regenerated from R3 medium, (D) explants regenerated from R4 medium.
Figure 11.
C. papaya “Eksotika” after one month: (A) explants regenerated from R1 medium, (B) explants regenerated from R2 medium, (C) explants regenerated from R3 medium, (D) explants regenerated from R4 medium.
Table 1.
Analysis of variance of the effect of media, 2,4-D concentrations and interaction between media and 2,4-D concentration on the average callus weight and percentage of somatic embryogenesis for induction of somatic embryogenesis in Eksotika.
Table 1.
Analysis of variance of the effect of media, 2,4-D concentrations and interaction between media and 2,4-D concentration on the average callus weight and percentage of somatic embryogenesis for induction of somatic embryogenesis in Eksotika.
| | Average Callus Weight | Percentage of Somatic Embryogenesis |
|---|
| | F | p-Value | F | p-Value |
|---|
| Media (M) | 20.708 | 0.000 | 11.595 | 0.001 |
| 2,4-D Concentration (C) | 2.186 | 0.102 | 0.385 | 0.765 |
| M * C | 0.108 | 0.955 | 0.774 | 0.514 |
Table 2.
Comparison of embryo size classes, somatic embryo (SE) developmental stage, number of SEs with callus formation at the base, and number of SEs that formed roots in M1–M5 media after 8 weeks of subculture. All values are means ± SD.
Table 2.
Comparison of embryo size classes, somatic embryo (SE) developmental stage, number of SEs with callus formation at the base, and number of SEs that formed roots in M1–M5 media after 8 weeks of subculture. All values are means ± SD.
| Media | Large Embryos | Small Embryos | Somatic Embryo Developmental Stage | Callus | Root |
|---|
| Globular | Heart | Torpedo | Early Torpedo | Cotyledonary |
|---|
| M1 | 20.80 ± 4.266c | 27.20 ± 4.63a | 15.20 ± 2.25a | 5.20 ± 3.56b | 18.20 ± 5.22a | 6.40 ± 4.28b | 6.20 ± 1.64c | 3.6 ± 3.78a | 6.40 ± 1.151b |
| M2 | 30.40 ± 1.871b | 19.60 ± 3.72a | 11.00 ± 4.03a | 5.00 ± 2.55b | 18.80 ± 3.77a | 6.20 ± 3.42b | 13.60 ± 7.23ab | 1.00 ± 0.71ab | 12.20 ± 2.77ab |
| M3 | 31.00 ± 5.339b | 17.80 ± 4.28a | 11.00 ± 3.84a | 7.00 ± 3.61ab | 13.60 ± 5.94a | 4.20 ± 2.59b | 16.40 ± 5.60a | 1.00 ± 1.23ab | 13.60 ± 2.89ab |
| M4 | 37.00 ± 7.810b | 26.00 ± 2.37a | 9.60 ± 1.28a | 8.80 ± 3.97ab | 17.60 ± 1.67a | 13.80 ± 7.36a | 17.60 ± 8.02a | 1.20 ± 1.10ab | 10.20 ± 1.88ab |
| M5 | 48.80 ± 5.111a | 21.80 ± 6.96a | 14.00 ± 2.60a | 10.00 ± 1.23a | 20.00 ± 7.94a | 16.40 ± 5.51a | 17.00 ± 8.00a | 0.00 ± 0.00b | 18.60 ± 5.26a |
| p-value | 0.00 | 0.323 | 0.261 | 0.080 | 0.415 | 0.003 | 0.069 | 0.071 | 0.068 |
| F-value | 12.612 | 1.248 | 1.428 | 2.439 | 1.033 | 5.912 | 2.580 | 2.554 | 2.591 |
Table 3.
Comparison of embryo size classes, somatic embryo developmental stage, number of SEs with callus formation at the base, and number of SEs that formed roots in M6-M9 medium after 8 weeks of subculture. All values are means ± SD.
Table 3.
Comparison of embryo size classes, somatic embryo developmental stage, number of SEs with callus formation at the base, and number of SEs that formed roots in M6-M9 medium after 8 weeks of subculture. All values are means ± SD.
| Media | Large Embryos | Small Embryos | Somatic Embryo Developmental Stage | Callus | Root |
|---|
| Globular | Heart | Torpedo | Early Torpedo | Cotyledonary |
|---|
| M6 | 27.00 ± 5.24a | 25.20 ± 4.22a | 13.60 ± 1.48a | 10.00 ± 2.12a | 14.80 ± 2.28a | 10.60 ± 5.94a | 7.20 ± 1.79b | 6.20 ± 3.49a | 5.60 ± 2.07a |
| M7 | 30.00 ± 1.87a | 26.60 ± 3.09a | 10.80 ± 2.77a | 10.60 ± 2.88a | 19.80 ± 2.68a | 11.60 ± 1.14a | 8.00 ± 3.67b | 3.00 ± 1.23a | 9.60 ± 5.03a |
| M8 | 32.80 ± 7.50a | 41.20 ± 11.44a | 26.20 ± 9.91a | 10.20 ± 4.21a | 15.00 ± 8.75a | 9.20 ± 2.28a | 13.20 ± 4.38a | 3.80 ± 2.17a | 9.80 ± 3.42a |
| M9 | 31.80 ± 7.79a | 27.60 ± 5.51a | 15.80 ± 2.68a | 5.60 ± 2.41b | 16.60 ± 5.86a | 11.20 ± 4.50a | 10.00 ± 2.35ab | 4.20 ± 4.15a | 12.20 ± 7.33a |
| p-value | 0.474 | 0.262 | 0.161 | 0.060 | 0.478 | 0.917 | 0.042 | 0.401 | 0.433 |
| F-value | 0.876 | 1.461 | 1.957 | 3.034 | 0.867 | 0.167 | 3.452 | 1.041 | 0.965 |
Table 4.
Comparison of means germination percentage after 6 weeks of germination. All values are means ± SD.
Table 4.
Comparison of means germination percentage after 6 weeks of germination. All values are means ± SD.
| Media | Mean ± SD | F Value | p-Value |
|---|
| G1 | 53.60 ± 4.60 | 3.881 | 0.084 |
| G2 | 42.40 ± 4.38 | | |
| G3 | 56.80 ± 5.90 | 2.113 | 0.184 |
| G4 | 46.40 ± 5.40 | | |
| p-value | 0.144 | | |
| F-value | 2.07 | | |
Table 5.
Comparison of means survival percentage after 6 weeks in elongation media. All values are means ± SD.
Table 5.
Comparison of means survival percentage after 6 weeks in elongation media. All values are means ± SD.
| Media | Mean ± SD | F Value | p-Value |
|---|
| EL1 | 43.37 ± 6.13a | 2.134 | 0.182 |
| EL2 | 55.95 ± 7.43a | | |
| EL3 | 44.09 ± 3.48a | 3.405 | 0.102 |
| EL4 | 57.80 ± 7.04a | | |
| p-value | 0.188 | | |
| F-value | 1.80 | | |
Table 6.
Comparison of survival (%), root number, root length (cm), shoot length (cm), leaf number, and callus formation (%) at the base of SEs after 6 weeks of culture in different rooting media. All values are means ± SD.
Table 6.
Comparison of survival (%), root number, root length (cm), shoot length (cm), leaf number, and callus formation (%) at the base of SEs after 6 weeks of culture in different rooting media. All values are means ± SD.
| SEs Source | Medium Type | Survival (%) | Root Number | Root Length | Shoot length | Leaf Number | Callus Formation | |
|---|
| EL2 | R1 | 52.75 ± 5.75b | 2.25 ± 0.98a | 6.25 ± 2.63ab | 7.00 ± 2.45a | 4.25 ± 0.50a | 0.00 ± 0.00a |
| EL2 | R2 | 93.75 ± 4.16a | 2.50 ± 1.29a | 3.50 ± 1.73b | 4.75 ± 1.26a | 3.00 ± 1.41a | 14.50 ± 4.26a |
| EL4 | R3 | 83.5 ± 4.76a | 3.00 ± 1.16a | 10.25 ± 3.86a | 8.00 ± 2.16a | 4.50 ± 1.29a | 29.00 ± 3.41a |
| EL4 | R4 | 88.75 ± 4.00a | 3.75 ± 0.50a | 4.50 ± 1.29b | 7.00 ± 0.82a | 4.00 ± 0.82a | 0.00 ± 0.00a |
| Riboflavin | | | | | | | |
| F-value | | 14.816 | 0.097 | 3.050 | 2.670 | 2.778 | 2.890 |
| p-value | | 0.008 | 0.766 | 0.131 | 0.153 | 0.147 | 0.140 |
| PG | | | | | | | |
| F- value | | 0.178 | 1.421 | 7.975 | 0.750 | 0.429 | 2.890 |
| p-value | | 0.688 | 0.278 | 0.030 | 0.420 | 0.537 | 0.140 |
| Riboflavin X PG | | | | | | | |
| F-value | | 6.287 | 1.84 | 3.194 | 0.885 | 0.652 | 1.606 |
| p-value | | 0.004 | 0.174 | 0.044 | 0.497 | 0.635 | 0.224 |
Table 7.
Comparison of the average acclimatization (% ± SD) of germinated SEs after 6 weeks of growth in peat moss soil.
Table 7.
Comparison of the average acclimatization (% ± SD) of germinated SEs after 6 weeks of growth in peat moss soil.
| Explant Source | Acclimatization (%) | F-Value | p-Value |
|---|
| R1 medium | 55.11 ± 4.81c | 0.160 | 0.710 |
| R2 medium | 66.67 ± 6.29bc | | |
| R3 medium | 83.33 ± 4.81ab | 1.00 | 0.374 |
| R4 medium | 100.0 ± 00.00a | | |
| F value | 407.833 | | |
| p-value | 0.000 | | |
Table 8.
The treatments composition during the induction phase.
Table 8.
The treatments composition during the induction phase.
| Code of Treatment Media | Composition Solid Media Treatment (Per Litter Media) |
|---|
| | Media | 2,4-D (mg L−1) |
|---|
| IM1 | ½ MS | 2.5 |
| IM2 | ½ MS | 5 |
| IM3 | ½ MS | 7.5 |
| IM4 | ½ MS | 10 |
| IM5 | ½ WPM | 2.5 |
| IM6 | ½ WPM | 5 |
| IM7 | ½ WPM | 7.5 |
| IM8 | ½ WPM | 10 |
Table 9.
The treatments composition during the maturation phase.
Table 9.
The treatments composition during the maturation phase.
| Source of SEs | Code of Treatment Media | Composition Solid Media Treatment (Per Litter Media) |
|---|
| Media | PEG (%) | PG (mg L−1) |
|---|
| IM1 | M 1 | ½ MS | 0 | 0 |
| IM1 | M 2 | ½ MS | 2 | 0 |
| IM1 | M 3 | ½ MS | 4 | 0 |
| IM1 | M 4 | ½ MS | 8 | 0 |
| IM1 | M 5 | ½ MS | 12 | 0 |
| IM 3 | M 6 | ½ MS | 0 | 0 |
| IM 3 | M 7 | ½ MS | 0 | 1 |
| IM 3 | M 8 | ½ MS | 0 | 5 |
| IM 3 | M 9 | ½ MS | 0 | 10 |
Table 10.
The treatments composition during the germination phase.
Table 10.
The treatments composition during the germination phase.
| Source of SEs | Code of Treatment Media | Composition Solid Media Treatment (Per Litter Media) |
|---|
| Media | AC (0.05%) |
|---|
| M5 | G 1 | ½ MS | √ |
| M5 | G 2 | ½ MS | 0 |
| M8 | G 3 | ½ MS | √ |
| M8 | G 4 | ½ MS | 0 |
Table 11.
The treatments composition during elongation phase.
Table 11.
The treatments composition during elongation phase.
| Source of SEs | Code of Treatment Media | Media |
|---|
| G1 | EL 1 | ½ MS |
| G2 | EL 2 | ½ MS |
| G3 | EL 3 | ½ MS |
| G4 | EL 4 | ½ MS |
Table 12.
The composition of treatment media during the rooting phase.
Table 12.
The composition of treatment media during the rooting phase.
| Source of SEs | Code of Treatment Media | Composition Solid Media Treatment (Per Litter Media) |
|---|
| Riboflavin 3.76 mg L−1 | PG 7.9 mg L−1 |
|---|
| EL2 | R 1 | 0 | 0 |
| EL2 | R 2 | √ | 0 |
| EL4 | R 3 | 0 | 0 |
| EL4 | R 4 | 0 | √ |